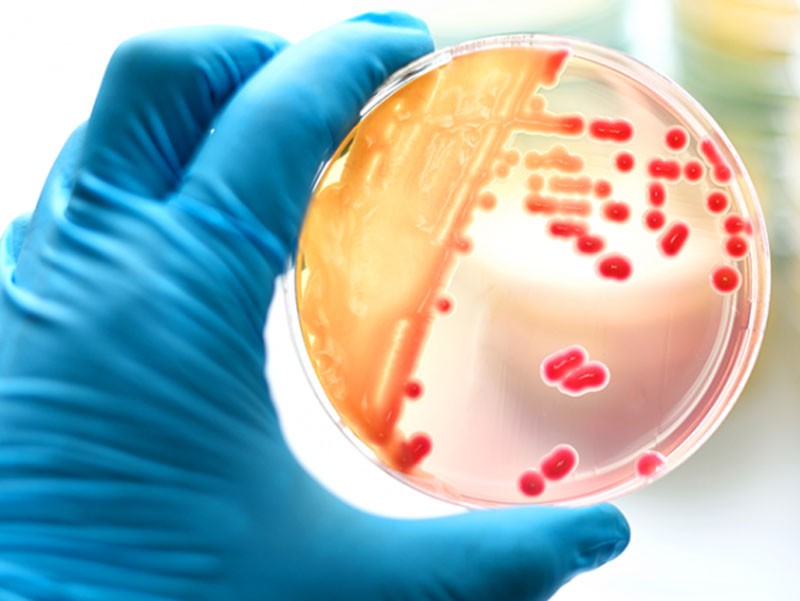
خواص بسیار عالی گزانگبین، خاصیت ضدمیکروبی

خواص گز انگبین
خواص گز انگبین بر هیچ کس پوشیده نیست؛ اما ممکن است این سوال برای برخی از افراد به وجود بیاید که گزانگبین چیست؟ چه ویژگیهایی دارد؟
گزانگبین یک ماده بسیار خوش طعم و خوش عطری است، که باعث میشود، طعم بسیار جذابی برای شما به وجود میآید.
استفاده از انگبین در گز حاصیت گز را چندین برابر میکند. از ویژگیهای گز خوب داشتن گزانگبین مرغوب است که بهترین برند گز اصفهان از گزانگبین مرغوب برای تهیه گز استفاده میکند.
معمولاً گزانگبین در کتابها و منابع مختلف نامهای متفاوتی دارد.
با نام انگبین گون، گزگزو، طرفا، گز مازج، خشک انگبین، گز علفی، گز خوانسار و من و السوی و موارد دیگر است.
این گیاه در مناطق کوهستانی خوانسار رشد میکند.
به دلیل اینکه خودرو است، میتواند مزیتهای بسیار زیاد را برای افراد به وجود بیاورد. گزانگبین ارزشمند توسط یک حشره بسیار کوچکی به نام پسیل گز آماده شده است، در اختیار افراد قرار میگیرد.
هر سال زمانی که فصل تابستان آغاز میشود، میلیونها حشره در کوههای خوانسار اطراف گیاههای گون جمع میشوند، شیره آن را میمکند و آن را تبدیل به یک گزانگبین میکنند.
ملیتهای بسیار زیادی برای گز انگبین وجود دارد، که به همین دلیل افراد به دنبال تهیه آنها هستند.
گزانگبین به عنوان یک ماده خوراکی خوش طعم به حساب میآید. خواص دارویی بسیار زیادی دارد.
گزانگبین خاصیت آنتی اکسیدانی و ضد میکروبی دارد.
این موضوع از ویژگی بسیار مهمی است، که درون گیاه گزانگبین وجود دارد. گزانگبین به صورت سنتی برای درمان اختلالات کبدی مورد استفاده قرار میگیرد.
ریشه و پوست این گیاه طبع سرد و خشک دارد. اما شهد آن طبع گرم و خشک دارد.
اگر بتوانید دم کرده گیاه گزانگبین را میل کنید، خواص ضد التهابی و ضد اسهال را به دست میآورید.
علاوه بر اینکه خاصیت ضد باکتری بسیار عالی دارد، در برابر مشکلات تنفسی بسیار مناسب هستند.

مهمترین خواص گز انگبین
از خواص بسیار عالی گزانگبین میتوان به موارد زیر اشاره نمود:
- برطرف کردن ناباروری
- جلوگیری از ابتلا به یبوست
- روانکنندگی
- تقویت قوای جسمی
- تقویت اعصاب
- دارای خواص ضد اسهال
- انعقاد کننده خون
- اثرات محرک روی سلامت کبد
- خاصیت ضد التهابی
- درمان انگل روده و معده میکروبی
- خاصیت ضدمیکروبی
- برطرف کردن مشکلات دستگاه تنفسی
در ادامه هر یک از موارد فوق را بررسی خواهیم کرد.
1. درمان ناباروری
یکی از مهمترین ویژگیهایی که درون گزانگبین وجود دارد؛ این است که نیت بسیار زیادی دارد. همین موضوع باعث میشود تا ناباروری را به عنوان یک ماده بسیار عالی برطرف کند.
یک نوع مادهای است که باعث ساختن اسپرم در مردان میشود، مشکلات ناباروری زوجین را برطرف میکند.
همین موضوع باعث میشود تا یک امیدی برای زوجین نابارور به وجود بیاید.

2. برطرف کردن یبوست و بواسیر
یبوست و عدم دفع غذایی یکی از مشکلاتی است که ممکن است تمامی انسانها با آن روبرو شوند.
همچنین طب سنتی یبوست را مادر تمامی بیماریها میدانند.
اگر درمان نشود بواسیر برای افراد به وجود میآید. باید بدانید یکی از خواص بسیاری برای گزانگبین وجود دارد؛ این است که میتواند یبوست را درمان کند.
از آسیبهای دیگر جلوگیری میکند.
اگر مشکلی برای دفع به وجود بیابد، یکی از گزینههایی که میتوانید از آن استفاده کنید، گزانگبین است.
3. خاصیت ملین و روانکنندگی
این نوع گیاه برای افرادی که دوست دارند، بهترین روان کننده به حساب میآید. به بهترین شکل ممکن مصرف آن میتواند برای شما توصیه شود.
4. بالا بردن قوای جنسی
همانطور که در موارد قبلی به این موضوع اشاره کردیم، گزانگبین مزیتهای بسیار زیادی دارد.
همچنین باعث میشود که قوای جنسی در مردان تقویت شود. ناباروری نیز درمان میشود.
همانطور که میدانید با استفاده از آن میتوانید انرژی مورد نیاز بدن را تامین کنید؛ به همین دلیل باعث تقویت قوای جنسی نیز میشود.
5. تقویت اعصاب
گزانگبین میتواند مزیتهای بسیار زیادی برای افراد به وجود بیاورد. ترکیباتی که درمان آن وجود دارد؛ ترشحات دوپامین در مغز افزایش میدهد.
بنابراین میتوانید روزانه با مشورت پزشک آن را مصرف کنید. با استفاده از آن تاثیرات مثبت روی زندگی خودتان آرامش اعصاب به دست میآورید.
6. خاصیت ضد اسهال
از مزیتهای بسیار عالی که گیاه گزانگبین دارد؛ این است که میتواند خاصیت ضد اسهال بودن داشته باشد.
این موضوع به دلیل پوسته گیاه گزانگبین است، میتواند باعث درمان اسهال کودکان شود.
7. منعقد کننده خون
این گیاه به عنوان یک خاک گیاه ضد میکروب به حساب میآید. برای جلوگیری از خونریزی ضعف و قوت کننده خون از سریهای بسیار عالی به حساب میآید.
همچنین باعث بهبود زخم میشود، میتوانید به صورت موضعی نیز از آن استفاده کنید.

8. سلامت کبد
طبق مطالعاتی محققان به دست آوردند، گیاه گزانگبین میتواند تاثیرات بسیار عالی روی سلامت و همچنین عملکرد کبد داشته باشد.
برای درمان اختلالات کبدی نیز به بهترین شکل ممکن از آن استفاده میکنند.
بیمارانی که کبد آسیب دیدهای دارند، به بهترین شکل ممکن میتوانند گزانگبین مصرف کنند. حتی بیماران مانند هپاتیت به صورت سنتی هم میتوانند از گیاه گز انگبین استفاده کنند.
9. خاصیت ضد التهابی
یکی از مزیتهای بسیار عالی که درون گزانگبین وجود دارد، که خاصیت ضد التهابی دارد.
برای درمان روماتیسم و درمان التهاب لثه عملکرد بسیار مفید و موثری دارد.
10. برطرف کردن انگل روده
خواص گزانگبین برای معده عالی است. یکی از خواص بسیار عالی گزانگبین، خاصیت ضدمیکرروبی آن است. گزانگبین به عنوان یک آنتی اکسیدان قوی به حساب میآید.
به همین دلیل برای درمان انگل روده میتواند مزیتهای بسیار عالی داشته باشد.
11. خاصیت ضدمیکروبی
همانطور که گفتیم گزانگبینهای که از برگها و گل تهیه میشود، میتواند زخمهایی که به صورت باز و زخمهایی که روی پوست وجود دارند را به بهترین شکل ممکن برطرف کنند.
اگر بتوانید از این گیاه برای کمپرس استفاده کنید میتوانید از خونریزی جلوگیری کنید.
این موضوع خواص ضد میکروبی بالایی دارد.
از دیگر خواص بسیار عالی گزانگبین که بدن انسانها بسیار زیاد به آن نیاز دارند و میتوانید برای جلوگیری از عفونت و بهبود یافتن سریع از آن استفاده کنید.
12. برطرف کردن مشکلات دستگاه تنفسی
یکی دیگر از خواص بسیار عالی گزانگبین، این است که میتواند با باکتریها و ویروسها مبارزه کند.
همین موضوع اگر به صورت دمنوش و جوشانده از آنها استفاده کنید، میتوانید با سرماخوردگی و مشکلات عفونت سینه استفاده کنید.
مردم بومی خوانسار از جوشانده این گیاه برای بخور در هنگام سرماخوردگی استفاده میکنند.
این گیاه میتواند باعث تنگی نفس، برطرف کردن درد قفسه سینه و ویژگی بسیار عالی دیگری نیز باشد.
به صورت کلی باید بدانید که استفاده از گز برای سلامتی انسانها مزیت بسیار زیادی دارد که میتواند در زندگی آنها تاثیرهای بسیار زیادی بگذارد.
بهتر است که استفاده از گز را در برنامه غذایی خودتان قرار دهید.




دیدگاهتان را بنویسید
می خواهید در گفت و گو شرکت کنید؟خیالتان راحت باشد :)